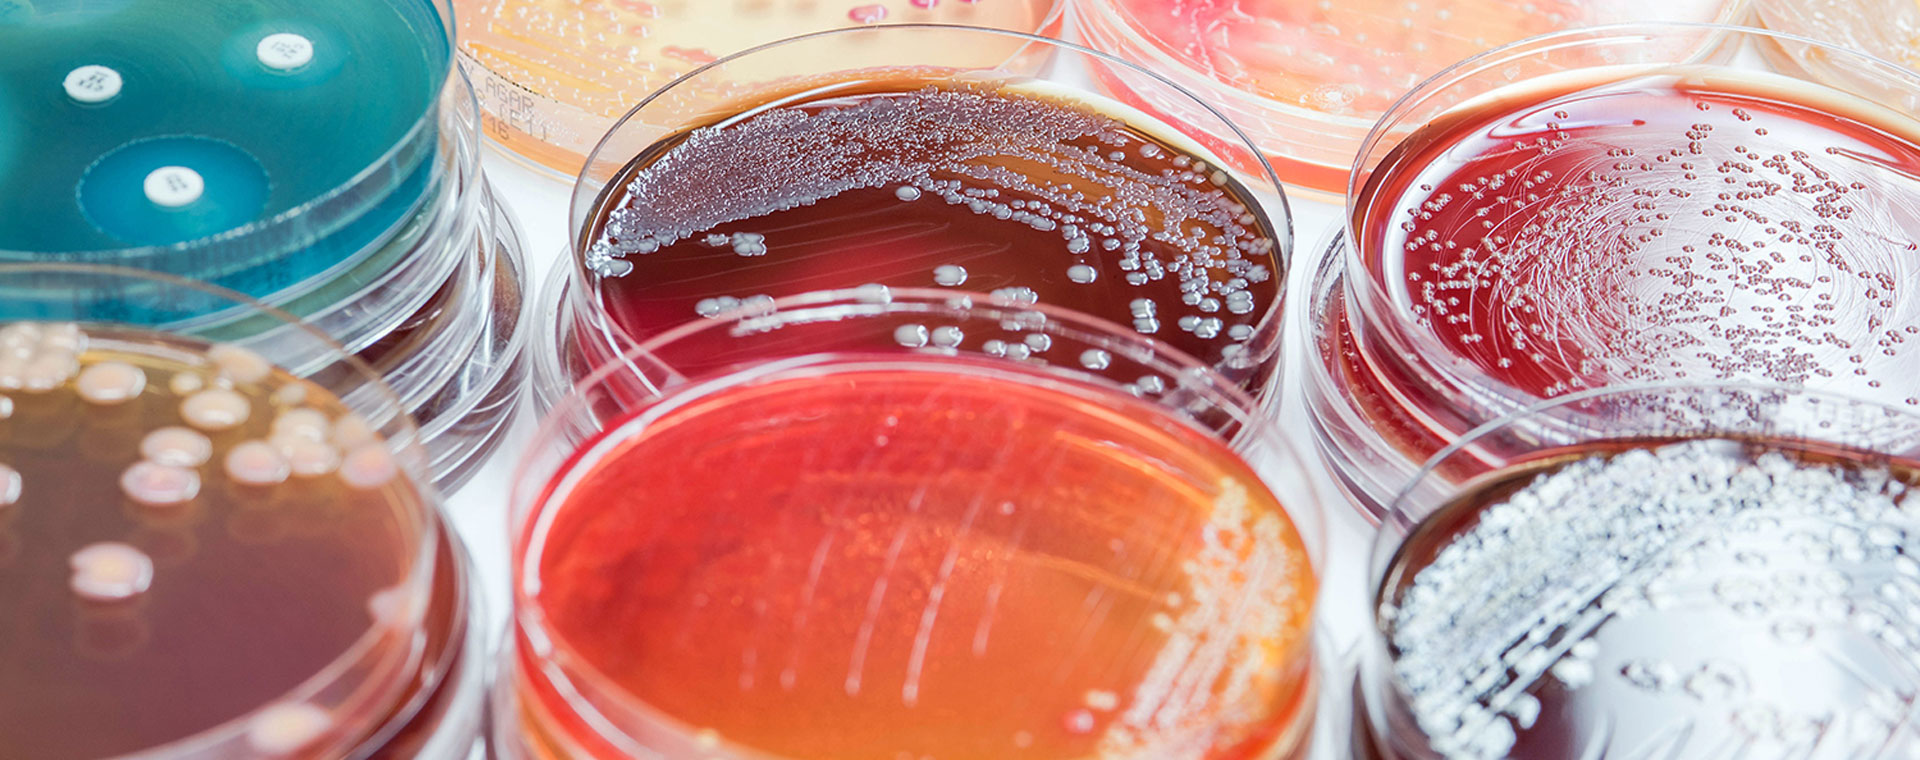
new-food-micro-webinar.jpg new-food-micro-webinar.jpg

News from standardization in water and food microbiology
Webinar
Thursday, October 9th, 2025
10–11 CEST

Email alerts

Free registration

Chat area

Certificate of attendance
Join our webinar to discuss revised food and water microbiology standards and the future outlook.
Bring yourself up to date with changes to existing standards:
- EN ISO 16140 Method validation and verification (larger sample sizes)
- EN ISO 6887 Sample preparation (amendment part 1, large sample sizes)
- EN ISO 7218 Microbiological examinations (general requirements and guidance)
- EN ISO 22174 PCR detection in food microbiology (general requirements and guidance)
- EN ISO 11133 Microbiological culture media (preparation, production, storage and performance testing)
- EN ISO 13136 Detection, isolation and characterization of Shiga toxin-producing Escherichia coli (STEC)
Learn about newly published standards:
- ISO/TS 16099 Water quality (general requirements, quality assurance and validation for PCR)
- EN ISO 13647 Water quality (colony count on R2A medium)
Presented by:

Barbara Gerten — Senior Scientist, Merck Life Science KGaA, Darmstadt, Germany
Chairwoman of the DIN working committee “Microbiology of the Food Chain” and member of the DIN working committee “Water Testing — Microbiology.” German delegate to CEN/TC 463 and ISO/TC 34/SC 9 for the development of standards in the field of food and water microbiology, including working groups "Method validation," "Culture media" and ISO/TC 147/SC 4 “Water quality — Microbiological methods.”



